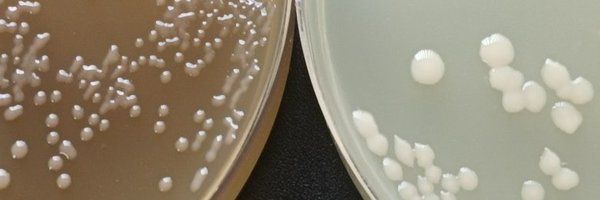
biotecmicrob Profile Banner

Microbial Biotechnology UM
@biotecmicrob
Followers
46
Following
57
Media
9
Statuses
43
🦠 Microbial Biotechnology Research Group 🧫 Department of Genetics and Microbiology
University of Murcia
Joined March 2024
Hello everyone! 👋🏻 We are the Microbial Biotechnology research group at the University of Murcia (@UMU). As an introduction, we leave you here a brief thread with our research focus. 👇🏻🧵Read more...
1
2
8
🚨 Thrilled to share our new paper in @OxUniPress #NucleicAcidsResearch! 🎉 Phages must outsmart bacterial defences to survive. We found that the first-injected genome region is key for escaping Type I RM restriction. 📖 https://t.co/coO0Up3rK8
#Microbiology #PhageDefense
0
3
8
Experience speeds up to 400+ Mbps to enjoy 4K streaming on multiple devices at once, working from home effectively, online gaming, social media browsing, and more. Order online in under 2 minutes.
168
501
3K
Finally, in the paper we had the great pleasure of collaborating with @PeterFineran and @SimonJacksonNZ! Couldn't be more grateful for their contributions!😊
0
0
1
INVESTIGACIÓN | Una investigación de la UMU describe un nuevo mecanismo por el que algunos virus evaden las defensas bacterianas 🦠🧫 🔗Más info: https://t.co/mJIVRgdLXu
0
6
10
¡Nos vemos en la SeCyT! 🌟 Esta mañana estaré acompañando al proyecto FaBioPat del ThinkinAzul de la @UMU en la caseta n.º 15 🔬🦠
0
2
3
Esta mañana estaremos en el puesto 15 de la Semana de la Ciencia y la Tecnología 2025 en el Paseo del Malecón de Murcia, divulgando acerca de biotecnología azul y biocontrol en acuicultura🐟🧫 ¡Os esperamos!😊 #SeCyT2025 @FundacionSeneca
0
0
0
Foto de familia de los participantes en la IX Reunión de la @RedFagoma celebrada en Oviedo. Un placer contar con tod@s vosotr@s #fagos #ciencia #debate y sobre todo #COLABORACIONES Nos vemos en la próxima X
0
8
17
Very very happy to share the publication of my first paper (and first one as first author too!) in @OxUniPress #NucleicAcidsResearch 🧫 Couldn't be more grateful to all my co-authors and collaborators😊
🚨 Thrilled to share our new paper in @OxUniPress #NucleicAcidsResearch! 🎉 Phages must outsmart bacterial defences to survive. We found that the first-injected genome region is key for escaping Type I RM restriction. 📖 https://t.co/coO0Up3rK8
#Microbiology #PhageDefense
1
2
8
🌟 Take-home message: It’s not just what sequences are in a phage genome, but where they are. This shows how bacterial defenses shape phage genome organization and evolution — insights that could guide smarter choices in phage therapy 🧬💊. #Microbiology #PhageDefense
1
0
2
🔍 Type I RM systems act like molecular scissors ✂️, cutting DNA at specific motifs. But not all phages are stopped… why? 🤔 👉 When the first-injected DNA lacks these motifs, the phage dodges the cut and successfully infects — even if motifs are present later in the genome.
1
0
2
🚨 Thrilled to share our new paper in @OxUniPress #NucleicAcidsResearch! 🎉 Phages must outsmart bacterial defences to survive. We found that the first-injected genome region is key for escaping Type I RM restriction. 📖 https://t.co/coO0Up3rK8
#Microbiology #PhageDefense
academic.oup.com
Abstract. Bacteriophages must evade bacterial defences to establish successful infections. Type I restriction-modification (RM) systems recognize specific
1
10
13
Happy International Microorganism Day! 🎉 We are celebrating the tiny powerhouses shaping our world, from gut bacteria to antibiotic-producing fungi. Let's make some noise for the microscopic! #InternationalMicroorganismDay
0
25
35
Ayer clausuramos el #XXXCongresoSEM. Fue una gran experiencia llena de muy buenos momentos. Nuestra enhorabuena a Malema y a todos los del equipo de la @ujaen por el gran trabajo realizado y la estupenda organización. ¡Nos vemos en Mallorca para el #XXXICongresoSEM!
0
7
21
Great to attend @SEMicrobiologia for the first time and share some of our work on bacterial immunity!!
Ayer pudimos asistir al Simposio Fagoma y nuevos sistemas anti-fago en el XXX Congreso de @SEMicrobiologia 🦠 Una gran oportunidad escuchar a todos los ponentes que participaron; José Antonio Escudero, Josefa Antón, Rafael Pinilla-Redondo y Alfred Fillol😊
0
6
28
Nuestra doctoranda Andrea Martínez Cazorla ha presentado una comunicación oral en el #CongresoSEM2025 de @SEMicrobiologia, consiguiendo el Segundo Premio de la SEM a Mejor Comunicación Oral. ¡Enhorabuena!👏🏽👏🏽
Esta semana he acudido junto con mis compañeros de @biotecmicrob al XXX Congreso de la @SEMicrobiologia en Jaén🦠🧫 He podido presentar una comunicación oral sobre mi trabajo de tesis, recibiendo el Segundo Premio de la SEM a Mejor Comunicación Oral. ¡Muy contenta y agradecida!😊
0
3
6
Muy contentos de poder acercar nuevos fagos infectivos CLP a Jaén en el poster de nuestra estudiante de TFM, Marina García🦠🐟📄 #CongresoSEM2025 @SEMicrobiologia
0
3
5
Nuestro doctorando Víctor Andrés González ha expuesto un póster acerca de su trabajo de tesis en el #CongresoSEM2025 de @SEMicrobiologia en Jaén 🧫📄
Estos días he estado disfrutando del #CongresoSEM2025 de @SEMicrobiologia. ¡Un placer aprender y compartir con tanta gente apasionada por la microbiología! 🦠✨
0
2
4
Ayer pudimos asistir al Simposio Fagoma y nuevos sistemas anti-fago en el XXX Congreso de @SEMicrobiologia 🦠 Una gran oportunidad escuchar a todos los ponentes que participaron; José Antonio Escudero, Josefa Antón, Rafael Pinilla-Redondo y Alfred Fillol😊
0
7
8
Esta semana estamos en Jaén participando en el XXX Congreso de la @SEMicrobiologia . ¡Encantados de compartir ciencia, aprender y conectar con la comunidad microbióloga! 🧫🧬 #CongresoSEM #Microbiología #Jaén2025
0
3
3
🚀 New publication! Our research group presents in International Journal of Systematic and Evolutionary Microbiology (IJSEM) a new Pantoea species with plant growth-promoting traits. 🔬 📖 Read more here: https://t.co/mL2ZR4Tglo
#IJSEM #newpublication #microbiology @MicrobioSoc
microbiologyresearch.org
0
3
5